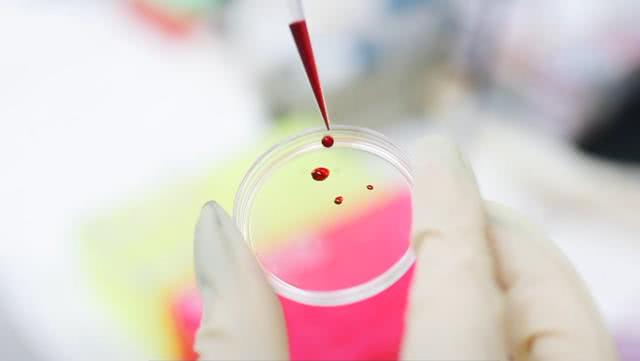
科学家发现了珍贵的黄金血液,全球仅43人,拥有者已救治多人

黄金血液

这就是血液中的黄金:成分血血小板.
图片尺寸4000x3000
比熊猫血还罕见的血型种类,世界上仅43人流淌,又称黄金血液,| 达林and
图片尺寸1146x716
黄金血液是什么颜色的
图片尺寸724x1280
可是有很多人不知道在世界上还有着另一叫更加珍贵的血液叫做黄金血
图片尺寸506x339
229毫克的黄金,假如将其血液中的全部黄金提取出来,能够组成一个边长
图片尺寸1919x1067
超级稀有的黄金血液!全世界不超过50人有!@油兔不二字幕组
图片尺寸1006x628
"黄金血"有多罕见?全世界仅3人拥有,它真能进化出超能力吗?
图片尺寸640x438
可能进化出超能力?_血型_血液_功能
图片尺寸1186x723
华夏健康幸福工程原来人的血液里有黄金
图片尺寸1600x1067
这是一个把黄金作为血液的女人
图片尺寸1080x1917
非洲"最昂贵"的血液,一滴血比黄金还贵?事实让人捧腹大笑_部落
图片尺寸700x505
先来说一说黄金血,我们都知道人体身上流淌着红色的血液,它是我们生命
图片尺寸1280x720
科学家发现了珍贵的黄金血液,全球仅43人,拥有者已救治多人
图片尺寸640x361
可能进化出超能力?_血型_血液_功能
图片尺寸1244x798
世上最罕见血型黄金血液全世界只有43人拥有极度珍贵
图片尺寸498x267
全世界只有6人的黄金血液捐献者响应召唤跨国献血的日常
图片尺寸461x346
世上最罕见血型"黄金血液"全世界只有43人拥有!极度珍贵
图片尺寸532x300
非洲"白人":血液被称作"液体黄金",警察24小时保护不离身
图片尺寸640x317
比熊猫血还要珍贵的血型全球仅40多人被称为黄金血液
图片尺寸600x400
可能是人类中的锦鲤了,每一滴血液都贵如黄金
图片尺寸660x350